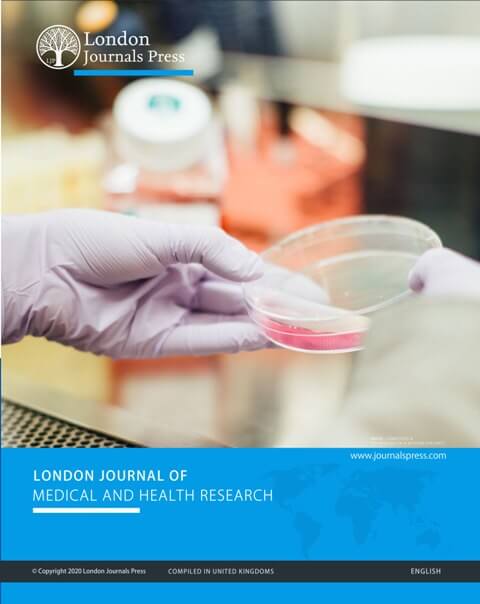
Hardcopy of LJMHR

Hardcopy of LJMHR
Original price was: £55.00.£25.00Current price is: £25.00. plus Taxes
The objective of this journal is to publish high-quality peer-reviewed research papers and articles including topics of Medical and Health Research. The journal is indexed in nearly all esteemed indexing organisation along with the British Library, University of Cambridge, Trinity College Dublin, Oxford University, The National Library of Wales, and National Library of Scotland.
Step 1. Journal Selection
Step 2. Author’s Details
Step 3. Research Details
-
Description
-
Additional information
The objective of this journal is to publish high-quality peer-reviewed research papers and articles including topics of Medical and Health Research. The journal is indexed in nearly all esteemed indexing organisation along with the British Library, University of Cambridge, Trinity College Dublin, Oxford University, The National Library of Wales, and National Library of Scotland.
Publication discounts are available for members of London Journals Press. Kindly get in touch to know the exact fee for your country and membership.
Note: This service is available only to eligible authors and articles only. You must confirm your eligibility from [email protected] before your payment.
| Weight | 0.7 kg |
|---|---|
| Dimensions | 37 × 27 × 4 cm |